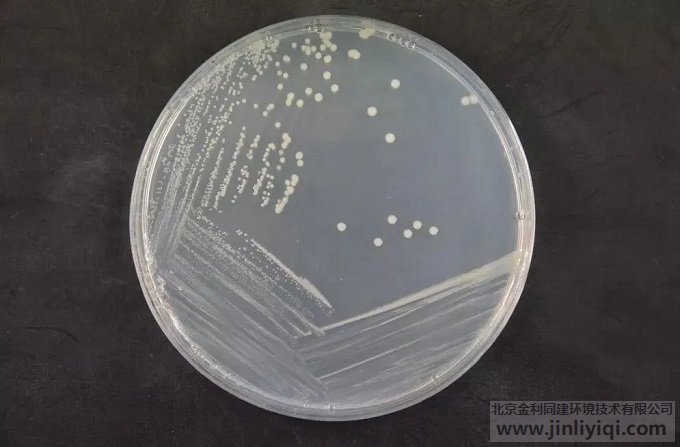
Ҭ���نΰ������B(y��ng)����

事件背景
10月5日,黑龍江省雞西市雞東縣興農(nóng)鎮(zhèn)某社區(qū)居民王某及其親屬9人在家中聚餐,疑似食物中毒致8人死亡,唯一幸存者也于19日不治身亡。調(diào)查得知,其間9人共同食用了自制酸湯子。該酸湯子食材已在冰箱冷凍一年,疑似該食材引發(fā)食物中毒。經(jīng)醫(yī)院化驗(yàn)檢測(cè),食物中黃曲霉素嚴(yán)重超標(biāo),初步判定為黃曲霉毒素中毒。
案情分析
曝光
時(shí)間曝光后迅速引起社會(huì)的廣泛關(guān)注并登上新聞熱搜。但是小編朋友圈里的很多從事食品安全的資深用戶(hù)均第一時(shí)間轉(zhuǎn)發(fā)并發(fā)表了自己的一些猜想——事件真相可能不是黃曲霉毒素中毒。我們所熟知的黃曲霉素,作一種天然的、致癌證據(jù)非常充分的強(qiáng)致癌物,一般污染玉米、花生、高粱、小麥、大米等,要造成這么高死亡率的急性中毒,可能性非常小。然而在專(zhuān)家們的分析下,新的矛頭指向了另外一種高致命性毒素——“椰毒假單胞菌”發(fā)酵產(chǎn)生的米酵菌酸毒素。
印證
案件發(fā)生后,黑龍江省衛(wèi)生健康委員會(huì)12日發(fā)布的最新信息,雞西食物中毒事件經(jīng)流行病學(xué)調(diào)查和疾控中心采樣檢測(cè)后,在玉米面以及患者胃液中檢出高濃度米酵菌酸,由此印證了這是一場(chǎng)由椰毒假單胞菌污染產(chǎn)生米酵菌酸引起的食物中毒事件。
揭秘真兇
其實(shí)早在8月1日,廣東省市場(chǎng)監(jiān)督管理局公眾號(hào)發(fā)布文章《廣東省市場(chǎng)監(jiān)督管理局發(fā)布消費(fèi)提醒:慎防米酵菌酸毒素中毒》。進(jìn)入高溫潮濕天氣,河粉、腸粉(卷粉)、陳村粉、粿條、等濕米粉容易受椰毒假單胞菌污染而產(chǎn)生米酵菌酸毒素。椰毒假單胞菌在自然界普遍存在,若米面食品未及時(shí)冷藏保存或超過(guò)保質(zhì)期,食用引發(fā)米酵菌酸毒素中毒的風(fēng)險(xiǎn)增大。
米酵菌酸(Bongkrek acid)
米酵菌酸(Bongkrek acid)是一種結(jié)構(gòu)含有三個(gè)羧基的長(zhǎng)鏈羧酸。科學(xué)家在2019年發(fā)現(xiàn)了米酵菌酸能與ADP/ATP轉(zhuǎn)運(yùn)酶結(jié)構(gòu)中的受質(zhì)結(jié)合處結(jié)合,使得粒線(xiàn)體基質(zhì)內(nèi)的ATP無(wú)法與轉(zhuǎn)運(yùn)酶結(jié)合而無(wú)法離開(kāi)線(xiàn)粒體,進(jìn)而導(dǎo)致無(wú)法給細(xì)胞供能。目前該毒素中毒尚無(wú)特效解毒藥物,致死率為40-100%。以下就是殺手的真面目:

Fig.1 米酵菌酸與異構(gòu)體異米酵菌酸結(jié)構(gòu)式
椰毒假單胞菌培養(yǎng)菌落
但是再隱蔽地“作案”都蒙騙不了質(zhì)譜分析的“法眼”。賽默飛獨(dú)家Orbitrap™系列超高分辨率液質(zhì)聯(lián)用系統(tǒng)具有出色的分辨率、質(zhì)量精度、靈敏度及穩(wěn)定性,可以實(shí)現(xiàn)一針進(jìn)樣獲得樣品中所有化合物的高質(zhì)量精度一級(jí)/二級(jí)質(zhì)譜數(shù)據(jù),為高通量毒物篩查提供可靠準(zhǔn)確的數(shù)據(jù);結(jié)合一系列專(zhuān)用數(shù)據(jù)庫(kù)與數(shù)據(jù)處理軟件,能實(shí)現(xiàn)靈活簡(jiǎn)單的一站式篩查流程。以下分享來(lái)自用戶(hù)的案例:
米面類(lèi)基質(zhì)樣品采用目前較為成熟的QuEChERS快速高效凈化法對(duì)化合物進(jìn)行提取凈化,可以有效地去除樣品中脂質(zhì),蛋白質(zhì)等成分,再氮吹復(fù)溶濃縮后即可上機(jī)進(jìn)行LC-HRMS快速篩查分析。賽默飛基于最先進(jìn)的 Core Enhanced Technology(表面多孔增強(qiáng)核技術(shù))結(jié)合固定相鍵合,以及耐受 100% 水柱填料特性, Thermo Scientific™ Accucore aQ HPLC 色譜柱能夠提供高效分析真菌毒素類(lèi) 、有機(jī)酸類(lèi)化合物的色譜解決方案,顯著提升實(shí)驗(yàn)室工作效率。

在乙腈-0.1%(v/v)甲酸水溶液的LC-HRMS條件下米酵菌酸分析色譜圖(50 μg/L)如下:

使用Full Scan – ddMS2采集模式能同時(shí)獲取化合物一級(jí)、二級(jí)信息;亞PPM級(jí)質(zhì)量精度保證定性結(jié)果準(zhǔn)確性。

方法學(xué)考察結(jié)果如下表格,方法回收率為90.6-96.8%。方法特異性好,靈敏度高,分析速度快。

Note
面對(duì)日益復(fù)雜的食品安全問(wèn)題,賽默飛色譜與質(zhì)譜產(chǎn)品能夠提供全面的霉菌毒素解決方案及數(shù)據(jù)庫(kù),涵蓋黃曲霉毒素、嘔吐毒素、雪腐鐮刀菌烯醇、伏馬毒素等常見(jiàn)毒物。此外,基于液質(zhì)聯(lián)用技術(shù)的農(nóng)獸藥殘留、司法毒物、非法添加物等檢測(cè)解決方案也正攜手用戶(hù),守護(hù)人類(lèi)生命健康。



